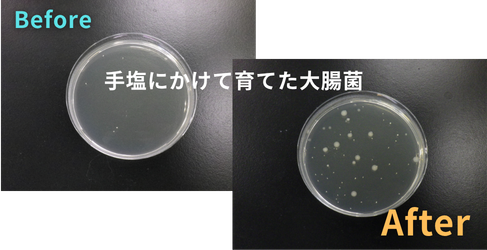

2026/02/20
■COLUMN〖試験担当者のひとり言〗~ お役立ちな独白14 乳酸菌飲料の生菌数を測定してみた
おさえておきたい基礎知識
2026/04/05

皆さんは、動物を飼育した経験がありますか?犬猫に限らず、学校で飼育したメダカやハムスター、最近はゲームなどでもいろんな動物を育てることができますね。手塩にかけて育てた自分のペットは世界一、いや宇宙一可愛いし、特別です。育てる目的により、与えるごはんや環境も変わってくるかと思います。例えば、ペットとしてなら健康面に気を使い、毛艶や成長ステージに合わせたごはんを用意することなど。一方、育成ゲームなら、目的に応じて繁殖や冒険などに必要なステータスを延ばすことになります。

実は、私たちも試験室の中でさまざまな生物を「育てて」います。ここで言う生物は、試験の微生物のことです。微生物も生き物なので、使用目的に応じて温度や栄養分などの環境を整える必要があります。
細菌やかびなどの微生物が増殖するためには、主に次の3つの条件が必要です。
細菌やカビなどの微生物は、これらの条件がそろうことで増殖します。どれか一つでも欠けてしまうと、十分に育つことができません。
微生物が育つのに必要な栄養分を含む液体、またはそれに寒天などを加えて固めたものを「培地」と呼びます。
培地は「微生物のごはん」とも言えます。菌の種類によって好みの栄養が違うため、目的に応じてさまざまな培地を使い分けています。
代表的な培地をいくつか紹介します。
| 培地 | 特徴 |
|---|---|
| 普通寒天培地 | 肉エキスとペプトンを含み、多くの細菌を広く培養できる基本的な培地 |
| ソイビーンカゼインダイジェスト培地 | 大豆やカゼイン由来の栄養を含み、多くの細菌がよく発育する培地 |
| サブローデキストロース寒天培地 | 糖分が多く、細菌よりもかびや酵母などの真菌が育ちやすい培地 |
| ポテトデキストロース寒天培地 | ジャガイモ由来のデンプンと糖を含み、かびの培養によく使われる培地 |
| 卵黄加マンニット食塩寒天培地 | 高濃度の食塩で他の菌の増殖を抑え、黄色ぶどう球菌を選択的に培養できる培地 |
| セトリミド寒天培地 | セトリミドにより他の菌の発育を抑え、緑膿菌を選択的に培養できる培地 |
| BCP加プレートカウント寒天培地 | 乳酸菌が産生する酸により紫から黄色に変化する特性を利用し、乳酸菌を判別しやすい培地 |
上記は一例ですが、細菌の培養に適したものや、かびの培養に適したものなど、目的によって使用する培地を変えています。また、卵黄加マンニット食塩寒天培地のように、他の菌の増殖を抑えながら特定の細菌だけを分離することができる選択培地もあります。どの培地を使用するかは、基本的には試験方法の規格で定められています。ただし、同じ組成の培地であってもメーカーによって発育の状況が変わることがあるため、使用するメーカーを統一することも重要です。
ソイビーンカゼインダイジェスト培地やポテトデキストロース寒天培地などは、名前の通り、原料に大豆や ジャガイモが使われています。ポテトデキストロース寒天培地は、ジャガイモと糖分、寒天からできています。ジャガイモに含まれる炭水化物により、かびの発育がよくなるそうです。
では、炭水化物と糖分が含まれていれば、かびは問題なく育つのでしょうか?
「じゃがいもじゃなくても、里芋でもいけるのでは?」という疑問も浮かんできます。
そこで次回は、さまざまな材料を使って寒天培地を手作りし、実際にかびを育ててみたいと思います!

バイオケミカルグループでは、さまざまな製品の抗菌・抗ウイルス試験や、消臭・防臭試験などを行っています。「該当する試験規格がなく、評価の進め方が分からない」「どう評価すればいいか分からない」など、評価方法のご相談から対応しておりますので、お気軽にお問い合わせください。
【コラム執筆担当】
一般財団法人ニッセンケン品質評価センター
ライフ アンド ヘルス事業本部 バイオケミカルグループ
本コラム「試験担当者のひとり言」は、毎月2回(5日・20日)更新しています。
次回もお楽しみに!
■関連記事
お役立ちな独白2 猫砂って汚いの? 猫砂の材質別生菌数からそれぞれの特性を検証
お役立ちな独白3 猫の汚れの実態は? もずくちゃんの生菌数をリアル検証しました
お役立ちな独白5 猫砂って汚いの?2 時間経過による菌の変化を調べてみた
おさえておきたい基礎知識
各種お問い合わせCONTACT
サービス全般についてのお問い合わせ
![]()
各種試験・検査に関するお問い合わせ、ご依頼はこちらから承ります。
エコテックス®に対するお問い合わせ
![]()
エコテックス®認証に関するお問い合わせ、ご依頼はこちらから承ります。
技術資料ダウンロード
![]()
各種試験・検査に関する技術資料が、こちらからダウンロードいただけます。
よくあるご質問
![]()
試験・検査などで、皆さまからよくいただく質問と回答をまとめています。
お電話からのお問い合わせはこちら